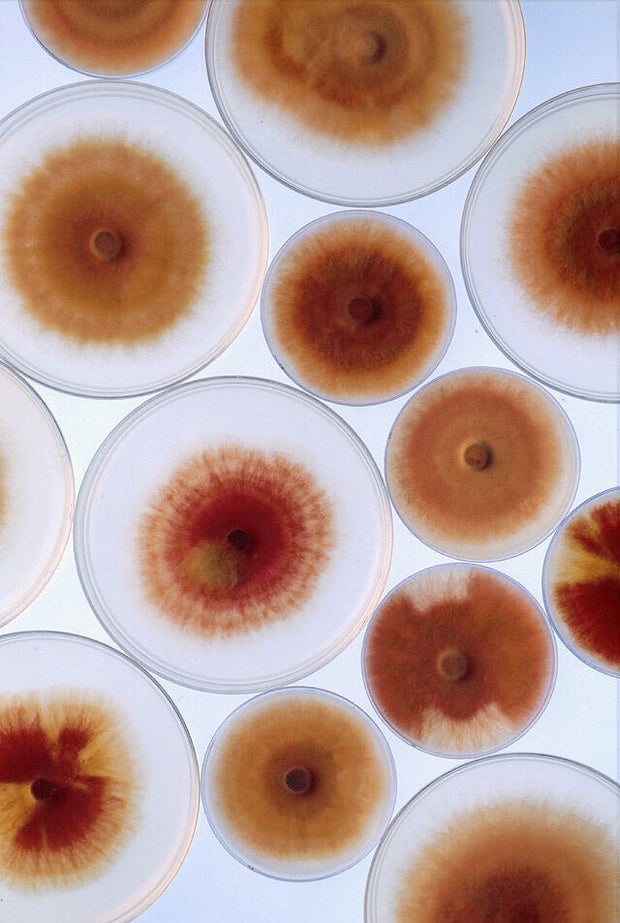
k8977-1.jpg

The fungus labeled a “potential agroterrorism weapon” in a recent arrest touted by the Trump administration likely originated in North America and is already widely prevalent around the country, a researcher who studied the fungus for the federal government says.
University of Michigan researcher Yunqing Jian and her boyfriend, Zunyong Liu, were charged with trying to smuggle strains of a fungus called Fusarium graminearum into the United States. Jian worked at the University of Michigan, according to officials, and Liu works at a Chinese university. The two have co-authored research into the fungus.Â
“I can confirm that the FBI arrested a Chinese national within the United States who allegedly smuggled a dangerous biological pathogen into the country,” FBI Director Kash Patel said Tuesday in a post on X.
Photo by Keith Weller, USDA Agricultural Research Service
According to charging documents in the case, Liu told customs officers he was trying to continue his research with the strains at the University of Michigan lab that Jian worked in, skirting the rules that require paperwork and safeguards to safely import fungi for studies.
F. graminearum is already widely prevalent across the U.S. in native grasses around the country as well as crops, scientists say. It spreads and thrives usually during wet weather, causing a common crop disease called Fusarium head blight or head scab, according to the U.S. Department of Agriculture’s Agricultural Research Service.
“It’s extremely prevalent in North America. It likely arose in North America, so it’s not like a foreign agent coming in. And it’s already causing a lot of problems in U.S. agriculture,” Harold Kistler, an adjunct professor at the University of Minnesota, told CBS News.
Photo by Keith Weller, USDA Agricultural Research Service
Kistler said scientists believe F. graminearum likely originated in North America, because all of its closest relatives have been found on the continent.Â
“Graminearum itself is distributed worldwide, and likely because of the distribution of grain from North America worldwide,” he said.
Kistler previously worked as a researcher for the USDA’s Agricultural Research Service, studying fungi like F. graminearum and the crop disease it causes. While at the agency, he co-authored research with Liu and Jian uncovering new molecular clues to how the disease might be mitigated.
“It’s a real problem. The problem is because there’s no naturally occurring resistance to the disease. And people have been trying for decades to find resistance. It’s just a tough nut to crack,” Kistler said of the head blight caused by F. graminearum.
Farmers in the U.S. rely on a number of methods to mitigate the risk of F. graminearum, including the use of fungicides, though scientists have worried about the possibility of mutations that could make the fungicides less effective.
“The fungicides are not cheap. So it’s extra cost to farmers. But it’s worth it because, without it, their crops could be completely lost. Not only due to yield reduction, but because what grain they may have would be contaminated with these toxins,” Kistler said.
Billions of dollars were lost to epidemics caused by the fungus in the 1990s, researchers and agriculture officials estimate. The Food and Drug Administration monitors for the toxins that are produced by fungi like F. graminearum, including deoxynivalenol, also called vomitoxin or DON, which can cause vomiting and diarrhea in humans who ingest too much of it.
“It is not possible to completely avoid the presence of DON in wheat. DON is sometimes found in wheat grown under normal weather conditions, however, the fungus thrives in cool, wet conditions,” the FDA said in a 2010 advisory to states and grain groups.
Kistler said U.S. distributors also test grain for the presence of the toxins to prevent there being too much of it in the food supply.
“If it’s too high, they will reject it. They won’t buy it. Or they will reduce the amount that they’ll pay for it. If it’s just marginal, they can blend it with grain that doesn’t have the toxin to get below the limit of what’s considered safe,” he said.